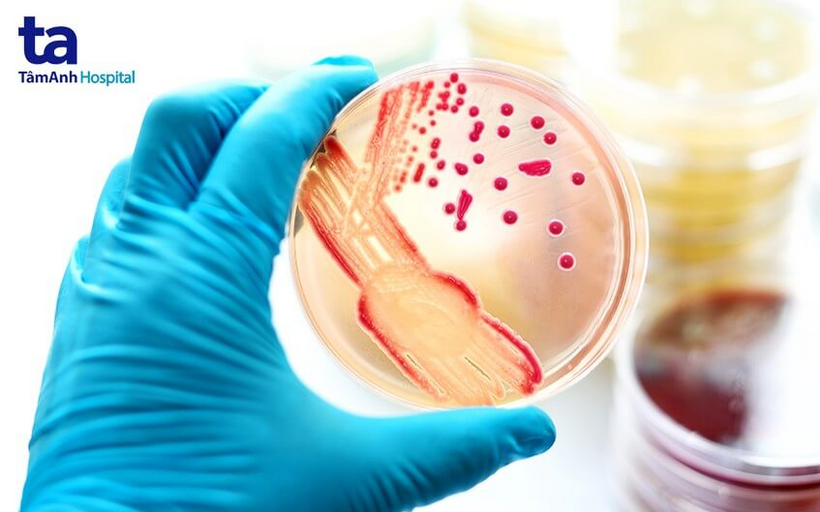
bien chung benh dau mua khi

Bệnh đậu mùa khỉ đã được Tổ chức Y tế Thế giới (WHO) tổ chức họp khẩn và đưa ra những cảnh báo về căn bệnh này đang bùng phát. Hiện bệnh đã xuất hiện tại 12 quốc gia trên thế giới như Anh, Tây Ban Nha, Bỉ, Ý, Pháp, Đức, Bồ Đào Nha, Thụy Điển, Mỹ, Canada, Australia và có nguy cơ lan sang nhiều nước khác.

Đậu mùa khỉ là gì?
Đậu mùa khỉ là một căn bệnh hiếm gặp, do virus có “họ hàng” với bệnh đậu mùa phổ biến gây ra. Người mắc bệnh thường có các triệu chứng như phát ban, sốt, đau đầu,…
Y văn ghi nhận các ca bệnh đậu mùa khỉ lây nhiễm trực tiếp qua tiếp xúc với người nhiễm (tiếp xúc với chăn ga gối trải giường, quần áo, khăn mặt, dịch tiết, giọt bắn đường hô hấp,…). Y văn chưa xác nhận việc bệnh đậu mùa khỉ có lây qua đường tình dục hay không. Tuy vậy, thông tin từ WHO ghi nhận bệnh có xuất hiện ở một số nam giới có quan hệ tình dục đồng tính. Trẻ em, người trưởng thành cũng là đối tượng có thể mắc bệnh.
Hầu hết những người nhiễm bệnh đều hồi phục sau vài tuần, tỷ lệ tử vong không cao. Tuy vậy, các yếu tố nguy cơ dẫn đến bệnh diễn tiến nặng, khả năng tử vong cao bao gồm: người mắc bệnh có tiếp xúc lâu dài với virus, trẻ em, người có hệ miễn dịch kém,….
Các nhà khoa học cho biết, căn bệnh này khó lây lan hơn so với dịch Covid-19. Tuy nhiên, bệnh đậu mùa khỉ vẫn có thể trở thành mối đe dọa sức khỏe toàn cầu nếu không có vaccine phòng ngừa kịp thời.
Nguyên nhân gây bệnh đậu mùa khỉ
Virus gây nên căn bệnh đậu mùa khỉ là gì? Theo các tài liệu, chủng virus này thuộc chi Orthopoxvirus trong họ virus Poxviridae, lần đầu tiên được phát hiện vào năm 1958. Do virus gây bệnh được phát hiện ở hai ổ dịch giống với căn bệnh đậu mùa xảy ra ở khỉ trong phòng nghiên cứu nên căn bệnh này cũng được gọi là bệnh đậu mùa khỉ. (1)
Tuy nhiên, cho đến thời điểm hiện tại thì khỉ không phải là tác nhân dẫn đến bùng phát dịch bệnh này. Theo WHO, nhiều khả năng loài gặm nhấm chính là nguồn lây lớn nhất nhưng vẫn chưa thể xác định chính xác.
Các triệu chứng của bệnh đậu mùa khỉ
Thời gian ủ bệnh
Nếu một người không may mắc bệnh đậu mùa khỉ thì thời gian ủ bệnh và phát hiện triệu chứng là bao lâu? Câu trả lời là, thông thường sau khi nhiễm virus gây nên bệnh đậu mùa khỉ thì thời gian ủ bệnh có thể từ 5 đến 21 ngày, tức là sau thời gian đó các triệu chứng đầu tiên của bệnh mới bắt đầu xuất hiện. Một số trường hợp, thời gian ủ bệnh kéo dài trong khoảng từ 7 đến 14 ngày. (2)
Triệu chứng bệnh đậu mùa khỉ
Các triệu chứng xuất hiện đầu tiên khi một người mắc bệnh đậu mùa khỉ bao gồm:
Sau khi có biểu hiện sốt, người bị bệnh đậu mùa khỉ có thể bị phát ban sau đó từ 1 đến 3 ngày. Các dấu phát ban có thể xuất hiện ở:
Các nốt phan ban ban đầu chỉ hơi sần trên bề mặt da và sau đó phát triển nghiêm trọng hơn, trở thành mụn nước, sưng to rồi dần chuyển sang mụn mủ rồi mới khô lại, đóng vảy và xẹp xuống. Thông thường, các triệu chứng bệnh đậu mùa khỉ sẽ kéo dài từ 2 đến 4 tuần rồi tự khỏi, người bệnh không cần thực hiện các biện pháp điều trị đặc biệt.
Đậu mùa khỉ lây qua đường nào?
Bệnh đậu mùa khỉ có thể lây trực tiếp khi tiếp xúc với máu, chất lỏng trong cơ thể, giọt bắn đường hô hấp, vết thương trên da hoặc niêm mạc của người bệnh (hoặc của động vật mắc bệnh).
Ngoài ra, ăn thịt động vật bị nhiễm bệnh, tiếp xúc với các vật dụng của người bệnh (chăn ga gối nệm, khăn mặt, quần áo,…) hoặc tiếp xúc với các tổn thương da của người bệnh cũng có thể khiến một người bị nhiễm bệnh đậu mùa khỉ. Vì thế, nếu sống chung với người đang mắc bệnh đậu mùa khỉ thì khả năng nhiễm bệnh thường khá cao.
Ngoài ra, căn bệnh này cũng có thể lây từ mẹ sang thai nhi và dẫn đến bệnh đậu mùa khỉ bẩm sinh. Trẻ sơ sinh tiếp xúc gần với mẹ trong quá trình sinh nở và sau khi sinh cũng có nguy cơ nhiễm bệnh cao nếu mẹ đang mắc bệnh.
Tuy tiếp xúc gần với người bệnh được xem như một yếu tố nguy cơ làm lây lan bệnh đậu mùa khỉ nhưng các chuyên gia cho rằng, vẫn chưa thể kết luận được việc căn bệnh này có lây truyền qua đường tình dục hay không. Cần thêm các nghiên cứu khác để xác định vấn đề này.
Chẩn đoán bệnh đậu mùa khỉ
Mặc dù bệnh đậu mùa khỉ đang có xu hướng bùng phát khiến nhiều người lo lắng việc chẩn đoán bệnh, tuy nhiên, trên thực tế, không phải trường hợp nào cũng cần kiểm tra, tầm soát bệnh. Chỉ nên thực hiện tầm soát bệnh đậu mùa khỉ nếu như:
Để thực hiện chẩn đoán bệnh đậu mùa khỉ, các bác sĩ sẽ thực hiện quy trình:
Tìm hiểu tiền sử bệnh
Các bác sĩ sẽ hỏi bạn về tiền sử bệnh xem đã tiếp xúc với người mắc bệnh hay chưa, từng mắc bệnh chưa hay có vừa đi qua các khu vực đang xuất hiện ca bệnh hay không,… Từ đó, sẽ xác định khả năng nhiễm bệnh đậu mùa khỉ của bạn.
Xét nghiệm
Ở bước tiếp theo, bác sĩ có thể chỉ định bạn thực hiện xét nghiệm PCR mẫu chất lỏng hoặc các vết thương trên da, từ đó phát hiện virus gây bệnh đậu mùa khỉ trong cơ thể.
Sinh thiết
Cuối cùng, nếu nghi ngờ nhiễm bệnh, bác sĩ có thể yêu cầu người bệnh thực hiện sinh thiết để xác định chính xác việc có nhiễm bệnh hay không.
Trong quá trình chẩn đoán, tầm soát bệnh thường sẽ không thực hiện xét nghiệm máu. Lý do là virus gây nên bệnh đậu mùa khỉ thường chỉ lưu lại trong máu một thời gian ngắn, khó phát hiện và chẩn đoán chính xác tình trạng bệnh.
Đậu mùa khỉ có nguy hiểm không, có gây tử vong không?
Đến đây, có lẽ câu trả lời cho câu hỏi đậu mùa khỉ là gì phần nào đã rõ. Vậy người mắc bệnh đậu mùa khỉ có nguy hiểm không, có thể gặp các biến chứng gì. Theo các tài liệu, các biến chứng thường gặp của bệnh này như sau:
Trước đây, tỷ lệ tử vong do bệnh đậu mùa khỉ dao động trong khoảng 11% so với số người mắc bệnh (trẻ em có tỷ lệ tử vong cao hơn). Trong thời gian gần đây, tỷ lệ tử vong dao động trong khoảng 3-6%.
Có thể nói, bệnh đậu mùa khỉ tuy khó lây lan giữa người với người hơn so với Covid-19 và các triệu chứng của bệnh cũng không quá nghiêm trọng nhưng đây vẫn là một căn bệnh nguy hiểm, cần có những biện pháp phòng ngừa phù hợp.
Nguồn: https://tamanhhospital.vn/benh-dau-mua-khi/
Người bị bệnh đậu mùa khỉ có nguy cơ bị nhiễm trùng máu dẫn đến tử vong
Điều trị bệnh đậu mùa khỉ
Tính đến thời điểm hiện tại, chưa có phương pháp hay thuốc đặc trị cho bệnh đậu mùa khỉ. Tuy nhiên, người bệnh không nên quá lo lắng bởi bệnh có thể thuyên giảm và tự khỏi mà không cần điều trị.
Một số loại thuốc được cho là có thể điều trị đậu mùa khỉ có thể kể đến như: Thuốc kháng vi rút cidofovir, thuốc kháng vi rút mới tecovirimat, thuốc nghiên cứu brincidofovir (CMX001),… – Vốn là các loại thuốc có hoạt tính chống lại virus đậu mùa trên khỉ. Tuy nhiên, hiện chưa có loại thuốc nào được nghiên cứu hoặc sử dụng trong các vùng dịch để điều trị bệnh đậu khỉ.
Đặc biệt, ở người bệnh từng tiêm vaccine ngừa bệnh đậu mùa thì vẫn có nguy cơ mắc bệnh đậu mùa khỉ. Tuy vậy, các triệu chứng bệnh thường nhẹ hơn, không diễn tiến nặng và ít nguy cơ để lại biến chứng, không cần can thiệp.
Phòng ngừa bệnh đậu mùa khỉ
Dù chưa ghi nhận các ca bệnh đậu mùa khỉ tại Việt Nam nhưng việc phòng ngừa bệnh vẫn nên được chú trọng. Một số biện pháp có thể áp dụng để hạn chế nguy cơ nhiễm bệnh bao gồm: (5)

Thường xuyên rửa tay giúp hạn chế nguy cơ mắc bệnh đậu mùa khỉ
Để đặt lịch khám và tư vấn, điều trị bệnh tại Hệ thống Bệnh viện Đa khoa Tâm Anh, Quý khách vui lòng liên hệ:
HỆ THỐNG BỆNH VIỆN ĐA KHOA TÂM ANH
Trước đây, bệnh đậu mùa khỉ chỉ xuất hiện tại Châu Phi nhưng chỉ trong thời gian ngắn gần đây, bệnh đã lây lan đến các quốc gia Châu Âu khác. Điều này khiến nhiều người trở nên lo lắng về tình hình bệnh. Các chuyên gia y tế cũng khuyến khích người dân không nên chủ quan, cần chủ động tiêm phòng đậu mùa và thực hiện các biện pháp phòng ngừa phù hợp, chủ động thăm khám nếu phát hiện các biểu hiện bất thường hoặc nghi ngờ tiếp xúc với người/động vật nhiễm bệnh.